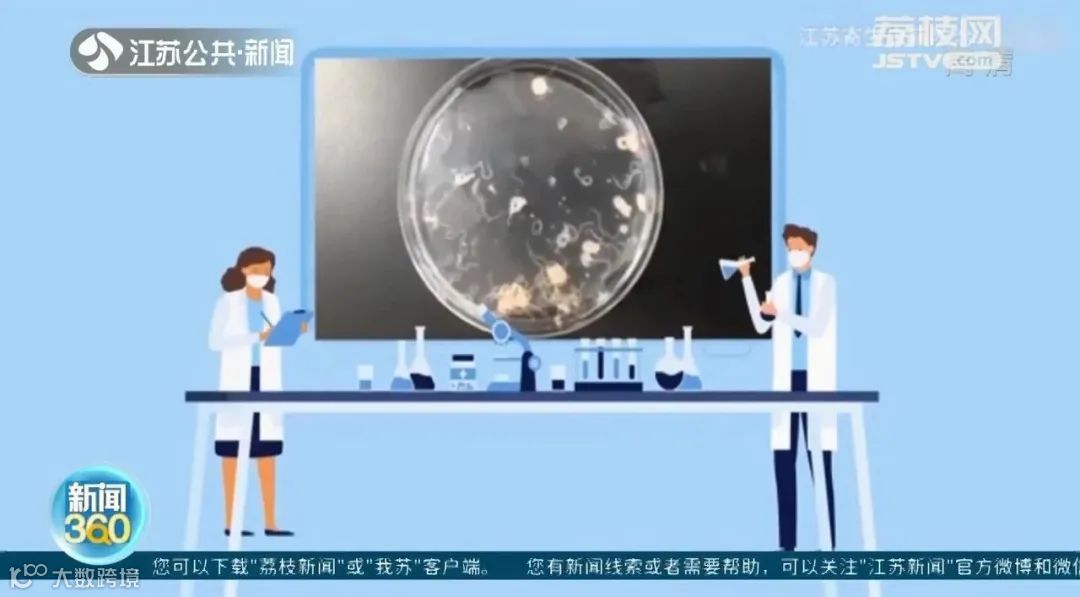

铁板鱿鱼是餐桌上比较常见的美食
但是如果没有熟透
吃了以后可能会感染异尖线虫
近日
江苏南通如东县采集了20条生鲜鱿鱼
有4条被检出异尖线虫

专家建议
食用鱿鱼建议去正规的餐馆或者摊点
铁板鱿鱼加工过程中
一定要煮熟煮透
不要为了贪图口感
而吃半生不熟的鱿鱼
号外!号外!

我们有粉丝群啦
加入我们,发现东阳趣事
不定期发放粉丝福利
举办有趣的线下活动
你也一起来玩呀
🔔🔔🔔
(添加好友小编会拉你进群)
end
来源 | 江苏新闻
校对 | 阿森 Zero
版权归原作者所有,如有侵权请及时联系我们


